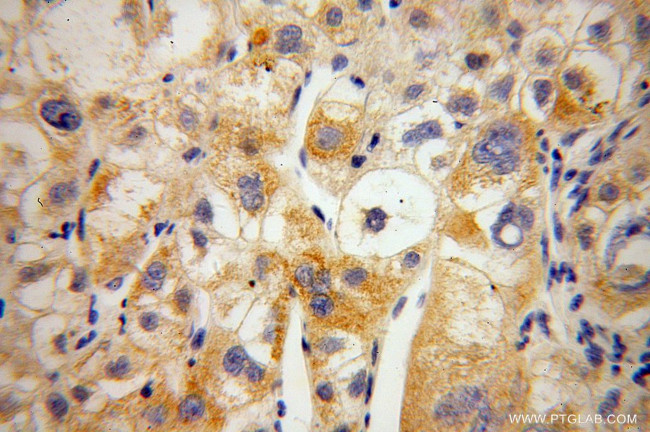
MIPOL1 Antibody in Immunohistochemistry (Paraffin) (IHC (P))

Search
Proteintech
MIPOL1 Polyclonal Antibody
{{$productOrderCtrl.translations['antibody.pdp.commerceCard.promotion.promotions']}}
{{$productOrderCtrl.translations['antibody.pdp.commerceCard.promotion.viewpromo']}}
{{$productOrderCtrl.translations['antibody.pdp.commerceCard.promotion.promocode']}}: {{promo.promoCode}} {{promo.promoTitle}} {{promo.promoDescription}}. {{$productOrderCtrl.translations['antibody.pdp.commerceCard.promotion.learnmore']}}
产品信息
14158-1-AP
种属反应
宿主/亚型
分类
类型
抗原
偶联物
形式
浓度
规格
纯化类型
保存液
内含物
保存条件
运输条件
产品详细信息
Immunogen sequence: MSRLQLAIE ERDEAIARAK HMEMSLKVLE NINPEENDMT LQELLNRINN ADTGIAIQKN GAIIVDRIYK TKECKMRITA EEMSALIEER DAALSKCKRL EQELHHVKEQ NQTSANNMRH LTAENNQERA LKAKLLSMQQ ARETAVQQYK KLEEEIQTLR VYYSLHKSLS QEENLKDQFN YTLSTYEEAL KNRENIVSIT QQQNEELATQ LQQALTERAN MELQLQHARE ASQVANEKVQ KLERLVDVLR KKVGTGTMRT VI (182-442 aa encoded by BC035870)
靶标信息
This gene encodes a coiled-coil domain-containing protein. The encoded protein may function as a tumor suppressor. A translocation that results in truncation of the protein encoded by this locus has been associated with mirror-image polydactyly, also known as Laurin-Sandrow Syndrome. Alternatively spliced transcript variants have been described.
仅用于科研。不用于诊断过程。未经明确授权不得转售。
篇参考文献 (0)
生物信息学
蛋白别名: CARD domain containing protein; CDC91L1; Mirror-image polydactyly gene 1 protein; unnamed protein product
基因别名: CCDC193; MIPOL1
UniProt ID: (Human) Q8TD10
Entrez Gene ID: (Human) 145282